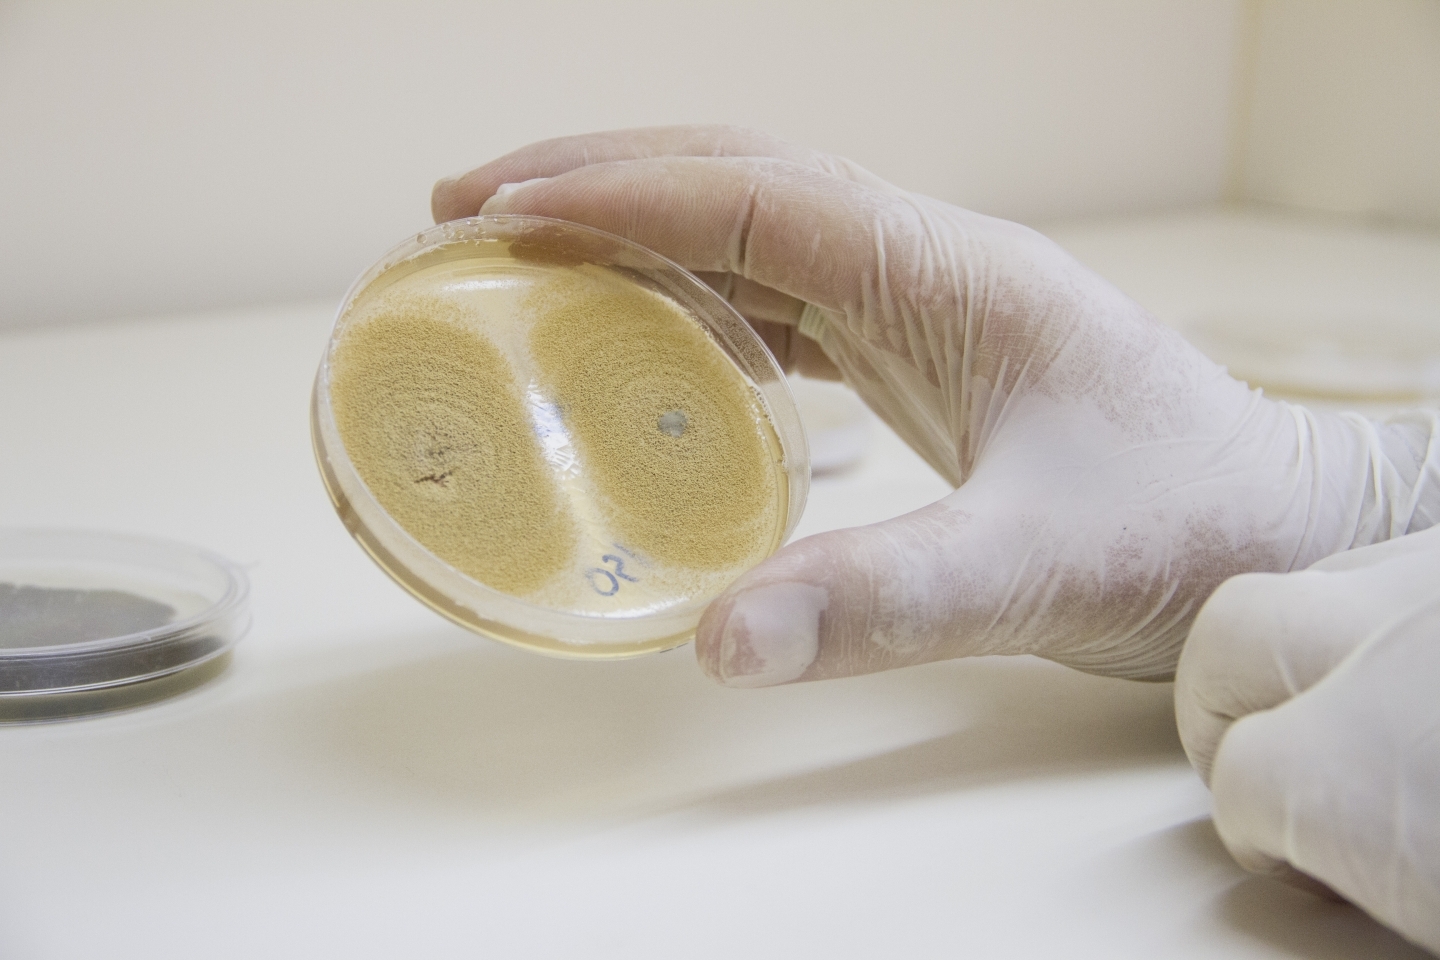
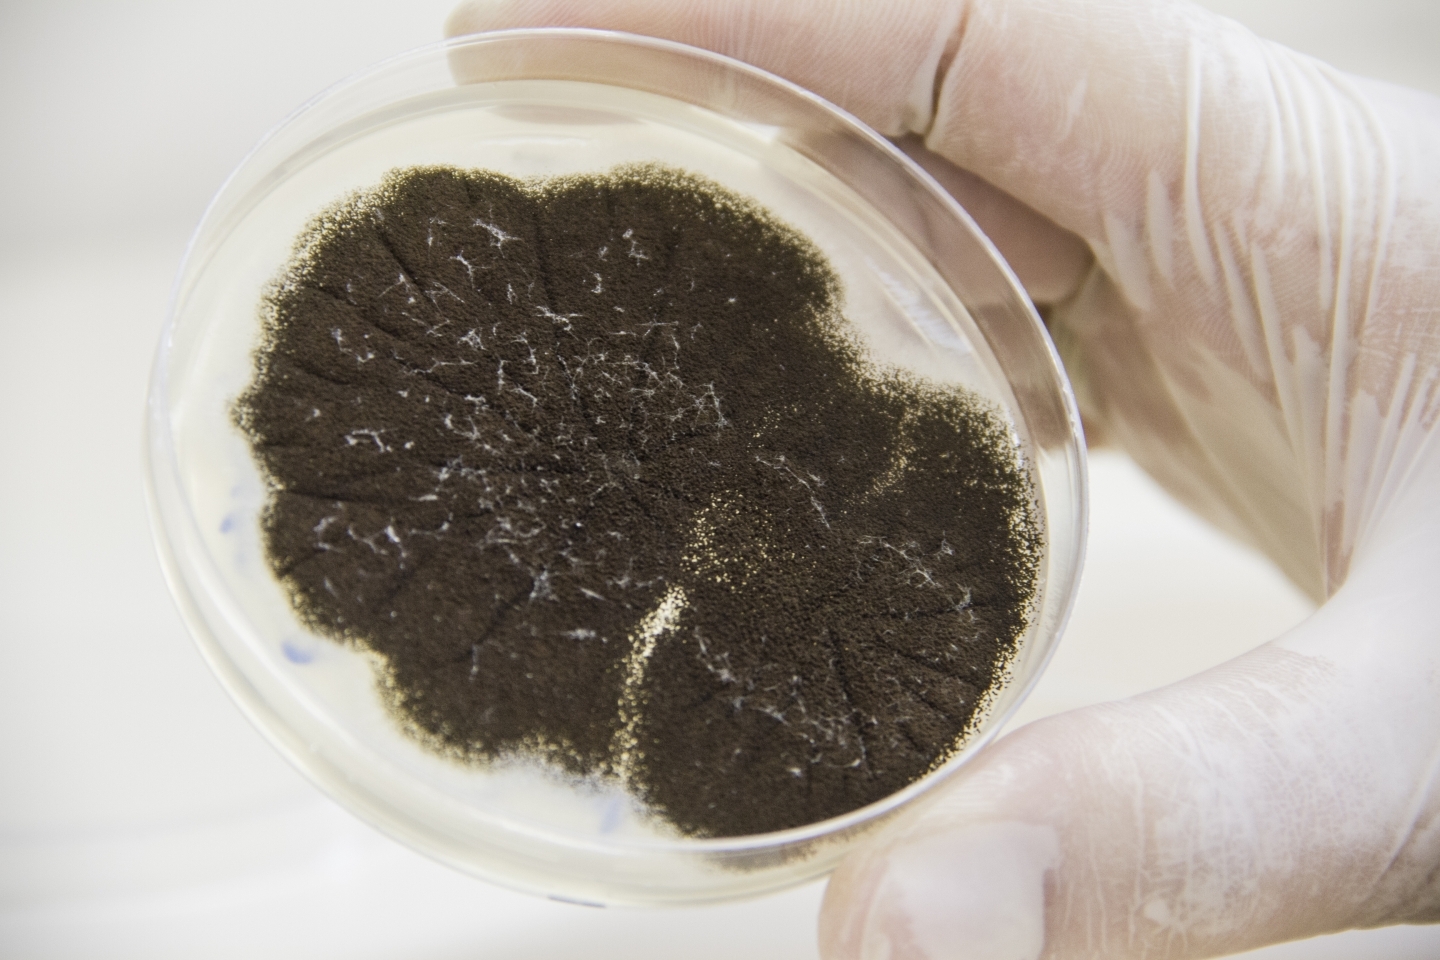

Com objetivo de controlar pragas de interesse sanitário e agropecuário, um grupo de pesquisa ligado ao Programa de Pós-Graduação em Biotecnologia da Univates (PPGBiotec) está testando formas de controle baseado no uso de microrganismos e extratos naturais. Entre as pragas avaliadas para serem controladas estão diferentes espécies de mosquitos que ultrapassam territórios, abrangendo o mundo todo. Conforme a pesquisa, a partir de fungos e extratos naturais o inseto pode ser morto ou repelido.
Visto como um grande problema por causa da picada e, principalmente, por muitos dos mosquitos testados serem agentes transmissores de doenças, o controle está sendo avaliado em diferentes estágios de vida do inseto. Pode-se dividir a pesquisa focada no controle dos estágios de vida na fase aquática (larva e pupa) e na fase adulta (o mosquito). O professor doutor Walter O. Beys da Silva, coordenador da pesquisa, afirma que a forma de controle das fases é totalmente diferente. ?Na fase aquática, trabalhamos testando extratos vegetais e bacterianos, que potencialmente podem conter moléculas com atividade inseticida. Já na fase adulta, os fungos são testados com agentes infectantes inseticidas, e os extratos, além dessa atividade, podem também ter propriedades repelentes?, explica. Beys da Silva ressalta que as estratégias utilizadas no controle dos mosquitos são biológicas e que, se comparado aos inseticidas químicos, trazem potencialmente um impacto muito menor para a saúde humana e o meio ambiente.
Além disso, para propiciar o contato do fungo e dos extratos com os diferentes estágios de vida do mosquito, os pesquisadores estão planejando armadilhas. ?Já estamos avaliando algumas possibilidades de desenvolvimento baseadas em modelos já utilizados, em que aplicaremos os fungos e extratos mais eficientes para o controle?, explica o professor.
Os fungos e extratos de plantas estão sendo coletados na região e preparados no laboratório para os experimentos. Os testes com larvas de mosquito, realizados no laboratório de Biotecnologia da Univates, já apresentam resultados. ?Temos selecionado um extrato de planta com uma atividade inseticida contra Aedes sp. muito interessante. Estamos em fase de determinação das melhores concentrações do extrato, além de investigar o possível mecanismo dessa atividade. Além disso, esse extrato será testado contra diferentes estágios larvais de Aedes aegypti que talvez seja, atualmente, o vetor de doenças mais importante mundialmente por conta da epidemia de zika, além da dengue, febre chikungunya e febre amarela?, afirma o pesquisador.
Na busca de melhor caracterização do mecanismo inseticida, Beys da Silva destaca que foi muito importante a colaboração de outros professores neste projeto, além das professoras integrantes da equipe inicial, Lucélia Santi e Marcia Goettert do PPGBiotec. ?Está se falando muito em esforço coletivo para o controle do mosquito da dengue e acredito que podemos fazer uma analogia nesta pesquisa, uma vez que buscamos uma parceria com os professores Eduardo Périco e Hamilton Grillo, do Museu de Ciências Naturais da Univates, que podem contribuir muito para que possamos avançar neste projeto?, complementa.
Texto: Ana Amélia Ritt